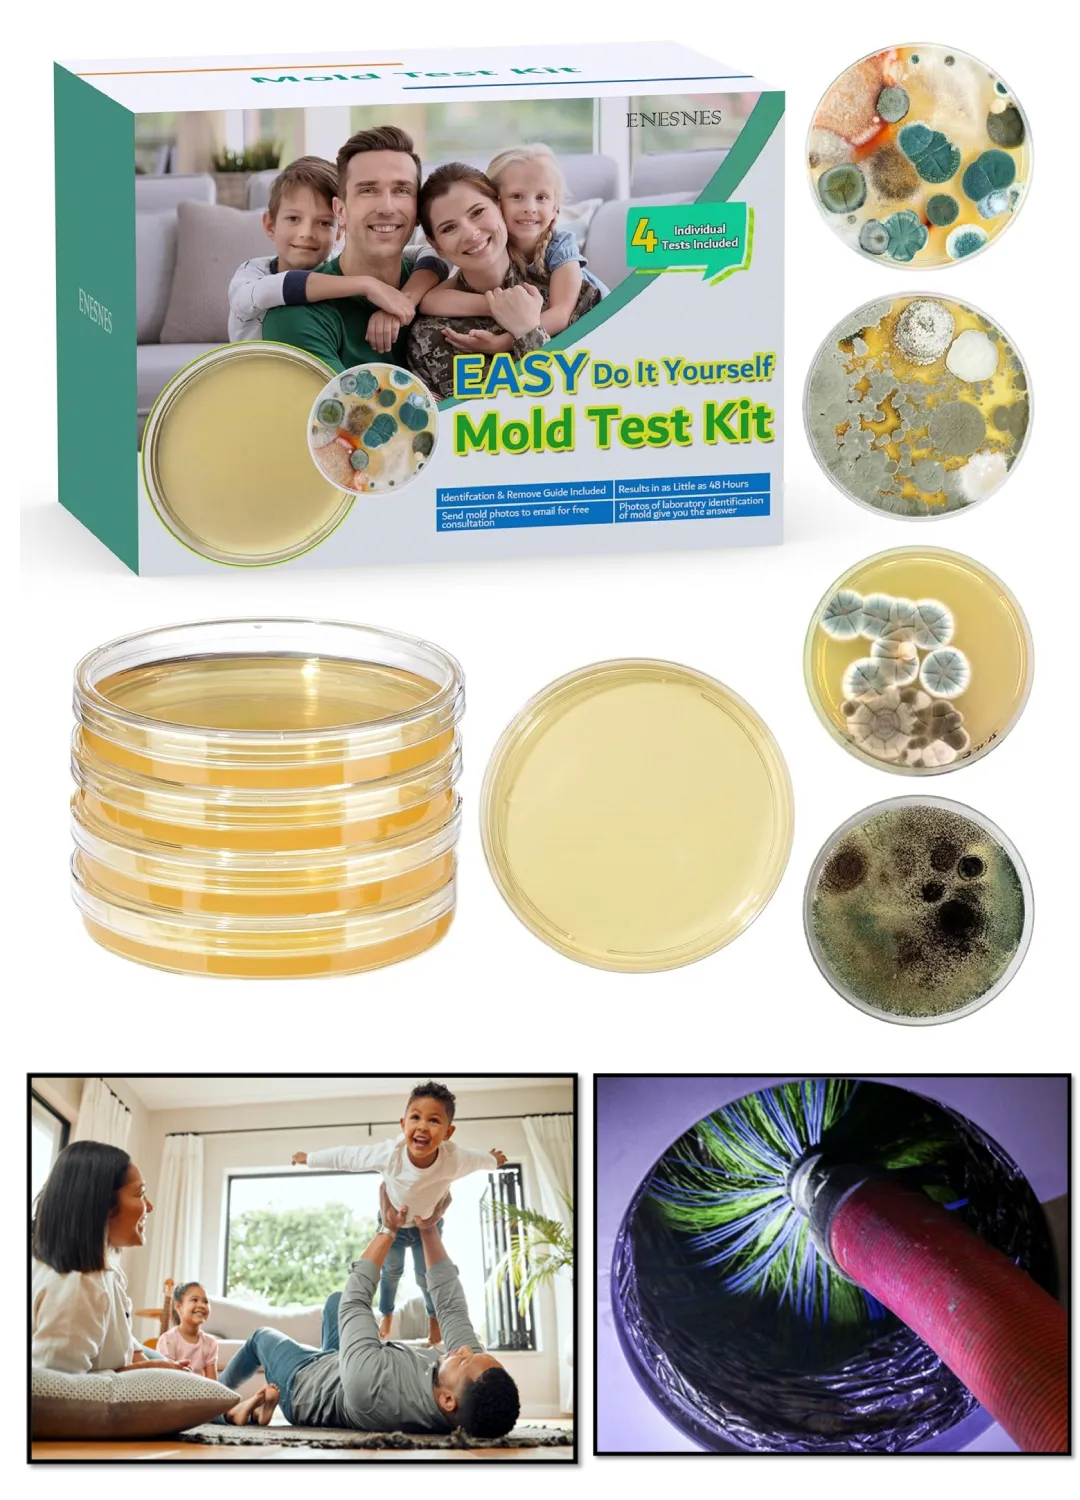

🚨 Don’t Wait – Spots Are Limited! Join before September 17, 2025
Find The Mold, Fix The Problem,
Reclaim Your Life.
Find The Mold. Fix The Problem. Reclaim Your Life.
FIND HIDDEN MOLD
In three expert LED sessions
Discover the mold you can’t see and protect the people you love
Live Schedule: Wednesdays at 7:30 PM EST (4:30 PM PT), September 17th, 24th, and October 1st, 2025 — each session includes a 60–75 minute lesson with live Q&A, replay access included.

Find
Locate Hidden Mold in Your Home

Test
Learn DIY Mold Testing

Remediate
Breathe Clean Air
Finding Hidden Mold — Your DIY Guide to a Healthier, Safer Home
Digital Book + 3-Part On-Demand Course + Bonus DIY Mold Test Kit

Finding Hidden Mold — Your DIY Guide to a Healthier, Safer Home
Digital Book + 3-Part On-Demand Course + Bonus DIY Mold Test Kit

Take Back Control of Your Home’s Health
Hidden mold is behind fatigue, allergies, poor sleep, and “mystery” symptoms. With 30+ years experience and 10,000+ inspections, this bundle shows step-by-step how to find mold, make smart decisions, and avoid costly mistakes.
Your recovery from mold illness won’t begin until you find hidden mold and stop the exposure.
Everything You Need to Start Today
Digital copy of Finding Hidden Mold (instant access)
3-Part On-Demand Masterclass
Bonus: DIY Mold Test Kit — 4 Petri plates shipped
$100 discount on 1:1 virtual consultation
Free Visual Contrast Sensitivity Test (VCST)
Printable checklists & red-flag guides
Immediate access to member materials
What You’ll Learn in 3 Transformative Sessions
Meet Your Instructor: Steve McLeod
Steve is a double-board-certified Indoor Environmental Consultant with 30+ years of experience and over 10,000 building investigations.
He’s served as an expert witness, guided thousands of homeowners and health professionals, and authored Finding Hidden Mold: Your DIY Guide to a Healthier and Safer Home.
Steve brings real-world insight, scientific clarity, and a deep commitment to solving America’s hidden mold health crisis.
Credentials:
Board-Certified Indoor Environmental Consultant (CIEC)
🧠 ISEAI Board-Certified Indoor Environmental Professional (IEP)
🧬 CIRSx Medically Important Assessments (MIA)
🌿 Master In green building science
🦠 Certified Microbial Consultant
🛠 Certified Mold Remediation Supervisor
🌬 Air System Cleaning Specialist
🔧 Ventilation System Mold Remediator
🏠 Residential & Commercial Mold Inspector
🏢 Founder: Indoor Environmental Systems & IAQ Health
📣 National Trainer for HVAC & IAQ Professionals
🌍 International Consultant & Expert Witness
Format: Virtual, weekly, 1 hour/session, live Q&A, recorded access

Meet Your Instructor: Steve McLeod
Steve is a double-board-certified Indoor Environmental Consultant with 30+ years of experience and over 10,000 building investigations.
He’s served as an expert witness, guided thousands of homeowners and health professionals, and authored Finding Hidden Mold: Your DIY Guide to a Healthier and Safer Home.
Steve brings real-world insight, scientific clarity, and a deep commitment to solving America’s hidden mold health crisis.
Credentials:
Board-Certified Indoor Environmental Consultant (CIEC)
🧠 ISEAI Board-Certified Indoor Environmental Professional (IEP)
🧬 CIRSx Medically Important Assessments (MIA)
🌿 Master In green building science
🦠 Certified Microbial Consultant
🛠 Certified Mold Remediation Supervisor
💧 Certified Water Damage Restoration Technician
🌬 Air System Cleaning Specialist
🔧 Ventilation System Mold Remediator
🏠 Residential & Commercial Mold Inspector
🏢 Founder: Indoor Environmental Systems & IAQ Health
📣 National Trainer for HVAC & IAQ Professionals
🌍 International Consultant & Expert Witness
Format: Virtual, weekly, 1 hour/session, live Q&A, recorded access
Learn It Once. Use It For Life.
Meet Your Instructor: Steve McLeod
Steve is a double-board-certified Indoor Environmental Consultant with 30+ years of experience and over 10,000 building investigations.
He’s served as an expert witness, guided thousands of homeowners and health professionals, and authored Finding Hidden Mold: Your DIY Guide to a Healthier and Safer Home.
Steve brings real-world insight, scientific clarity, and a deep commitment to solving America’s hidden mold health crisis.

Meet Your Instructor: Steve McLeod
Steve is a double-board-certified Indoor Environmental Consultant with 30+ years of experience and over 10,000 building investigations.
He’s served as an expert witness, guided thousands of homeowners and health professionals, and authored Finding Hidden Mold: Your DIY Guide to a Healthier and Safer Home.
Steve brings real-world insight, scientific clarity, and a deep commitment to solving America’s hidden mold health crisis.
Credentials:
Board-Certified Indoor Environmental Consultant (CIEC)
🧠 ISEAI Board-Certified Indoor Environmental Professional (IEP)
🧬 CIRSx Medically Important Assessments (MIA)
🌿 Master In green building science
🦠 Certified Microbial Consultant
🛠 Certified Mold Remediation Supervisor
💧 Certified Water Damage Restoration Technician
🌬 Air System Cleaning Specialist
🔧 Ventilation System Mold Remediator
🏠 Residential & Commercial Mold Inspector
🏢 Founder: Indoor Environmental Systems & IAQ Health
📣 National Trainer for HVAC & IAQ Professionals
🌍 International Consultant & Expert Witness
Format: Virtual, weekly, 1 hour/session, live Q&A, recorded access

Session 1
Mold basics, health, testing essentials
Learn how mold disrupts energy, sleep, mood, immunity—and even rewires your genes. This session breaks down the types of mold, the science of CIRS, and how to test your home safely and affordably.
Based on:
Chapters 1–3

Session 2
Room-by-room deep dive
Take a guided walkthrough of your home and discover the top hiding spots for hidden mold—bathrooms, HVAC systems, basements, kitchens, crawl spaces, and more. You’ll learn what tools to use and what signs to trust.
Based on:
Chapters 4–10

Session 3
Safe remediation & recovery
This session takes you inside real-world remediation—from what containment should look like to how to clean up without spreading spores. Learn when to DIY, when to hire pros, and how to avoid the most common and costly mistakes. We’ll cover HEPA tools, dry fogging, ductwork contamination, particle testing, and how to verify that your home is truly clean.
Based on:
Chapter 11 + Real Case Studies & Proven Tools
Not Sure If This Is You?
Take the quiz & download 10 Signs of Hidden Mold Growth guide
Answer 12 simple questions about your home & health
Get your personalized Mold Risk Score instantly
Receive a free Healthy Home Checklist after the quiz

The Cost of Waiting Is High
Save Money, Protect Health, Recovery Starts Here, Peace of Mind
What Learners Are Saying

"Surprisingly Easy to Learn"
I didn’t expect to learn so much in just three sessions. Steve makes complex stuff feel easy. Highly recommend!
- Emily B 06/01/25


"Air Quality Game-Changer"
We love this group! Truly experts, AND kind and helpful in every way. If you want to improve the air quality and safety in your home, you owe it to yourself and your family to connect with this group. We spent wasted money on a bogus mold assessment before we found IES. Thanks to Steve and Lori! We now feel confident that our home environment is a healthy one for our family.
David H. 12/19/24


"Highly recommend this"
I was a bit skeptical at first, but this masterclass was worth every penny. It’s practical, clear, and surprisingly engaging.
- Sarah P.


Steve McLeod, Dual Board-Certified IEP, ISEAI Member
📊 Stats: 30+ Years, Helped 1,000+ Families
🎖️Badges: ISEAI.org, functional medicine endorsements

Why This Bundle Works
Features: Complete digital book, on-demand 3-session course, DIY test kit, VCST + checklists, $100 consult discount
Advantages: Learn expert playbook, avoid mistakes, make smart DIY vs pro calls, validate progress with testing
Benefits: Financial peace of mind, clarity, better indoor air, support recovery
Start Your DIY Mold Solution — Only $57
For only $57, you’ll receive:
The complete digital book
A 3-part masterclass with step-by-step training
A DIY mold test kit (4 Petri plates) shipped to your home
Immediate access to start learning today
Bonus: $100 discount on a one-on-one virtual consultation for a customized plan
Free Visual Contrast Sensitivity Test (VCST)
Limited-Time Bonus: The DIY test kit, VCST, and $100 discount are only included for early sign-ups. Don’t miss it.
Don’t Wait – Spots Are Limited!
Join before September 17th, 2025
Frequently Asked Questions
What is included in the Mold Master Class Series?
The series consists of three live, interactive trainings held over three weeks. Each session covers a different aspect of finding and addressing hidden mold in your home.
Is this masterclass relevant if I rent instead of own?
Absolutely. Many inspection tips and recommendations are renter-friendly and focus on observation, low-cost tools, and surface-level improvements.
Is this class live?
Yes, live on Zoom with Q&A. Replays are available.
Do I need any special equipment or software to participate?
You’ll need a computer or mobile device with internet access. Sessions are hosted via Zoom (or a similar platform), so we recommend using a webcam and microphone for participation.
Will the sessions be recorded? Can I watch them later?
Yes, all sessions will be recorded. Registered participants will receive access to replays so that you can review the material at your convenience.
What if I miss a session?
No problem! You’ll have access to the recordings and all supporting materials for each session.
Is this class suitable for beginners?
Absolutely. The series is designed for all levels, whether you’re new to mold awareness or already have experience with home assessments.
Will there be opportunities to ask questions?
Yes, each session includes dedicated Q&A time, and you can also submit questions in advance or during the training.
How much time should I set aside each week?
Plan for 60–90 minutes per session, plus any additional time you’d like to spend reviewing materials or applying what you learn.
Will I receive any materials or resources?
Yes, you’ll get checklists, guides, and actionable resources to help you assess and improve your home.
Is there ongoing support after the series ends?
You’ll have access to the session recordings and resources. Additional support options may be available—details will be shared during the series.
How do I register, and what happens next?
Register through the provided link. You’ll receive confirmation and access details by email, along with reminders before each session.
Can I share my registration with a friend or family member?
Registrations are per household, but you may contact us if you’d like to transfer your spot to someone else. If you have any further questions, please don't hesitate to reach out—we’re here to help you create a healthier home.
🕒 Live Schedule: Wednesdays at 7:30 PM EST (4:30 PM PT), September 17th, 24th, and October 1st, 2025 — each session includes a 60–75 minute lesson with live Q&A, replay access included.
Copyrights © 2025 | Indoor Environmental Systems, Inc. All Rights Reserved. | Courses page | [email protected]
